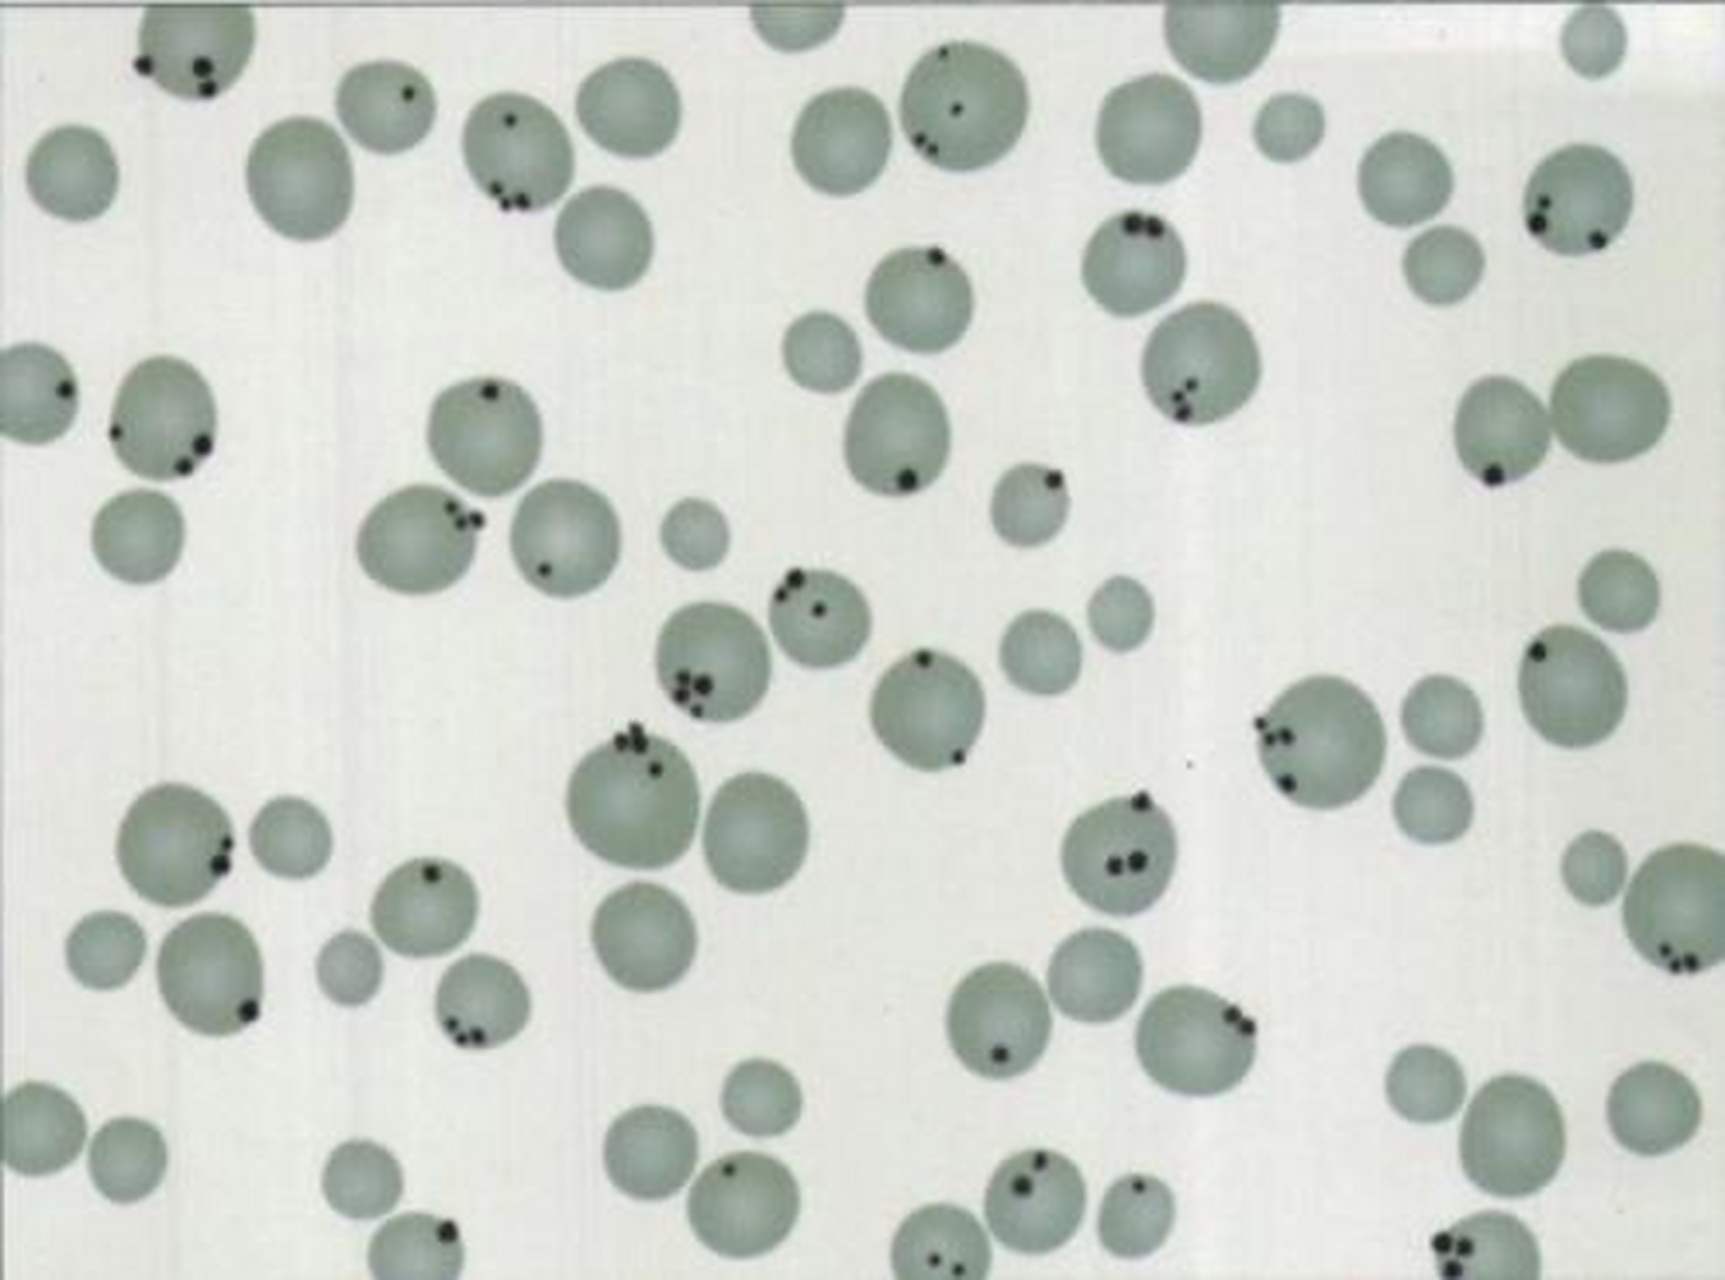
科普知识竞赛#变性珠蛋白小体检测(heinz小体)是一种变性血红蛋鬃

变性珠蛋白小体

变性珠蛋白小体
图片尺寸280x232
科普知识竞赛#变性珠蛋白小体检测(heinz小体)是一种变性血红蛋鬃
图片尺寸1725x1280
氧化剂药物致变性珠蛋白小体溶血性贫血一例_医学资讯_大夫e站
图片尺寸640x486
变形珠蛋白小体即heinzbody:是g6pd缺乏患者血样中加入乙酰苯肼于37
图片尺寸614x645
变性珠蛋白小体(heinz小体)
图片尺寸360x242
变形珠蛋白小体即heinzbody:是g6pd缺乏患者血样中加入乙酰苯肼于37
图片尺寸598x640
▼「含奥氏小体的中性分叶核粒细胞(apl治疗后患者外周血)」形态特征
图片尺寸1080x948
呈现圆形的层状,微黄或黄褐色,在前列腺中,淀粉样小体与胆固醇结合,可
图片尺寸750x564
随着不断的实验,发现朊病毒的蛋白质不能抵抗高浓度的蛋白质强变性剂
图片尺寸1200x745
图3-1 1~6 卵磷脂小体 1~3光镜高倍镜下卵磷脂小体,4~5相差高倍镜
图片尺寸1557x803
医学检验·检查项目:变性球蛋白(heinz)小体生成试验_课件模板
图片尺寸800x600
病理切片15
图片尺寸1079x807
从病因学角度分析,tha和ida均是由不同原因导致红细胞内血红蛋白合成
图片尺寸1280x966
示大量畸形红细胞,呈细胞膜缺如或球形红细胞,系变性珠蛋白小体(heinz
图片尺寸460x412
弥漫性硬化性肾小球肾炎
图片尺寸1080x810
重度贫血状态,根据红细胞相关参数可归类至小细胞低色素性贫血大类
图片尺寸555x346
3.卡波氏环变性珠蛋白小体是红细胞内变性珠蛋白的包涵体.
图片尺寸600x400
hb内部的-sh也被氧化导致hb变性,变性后 形成珠蛋白
图片尺寸1080x810
hgb通道 亲水基 疏水基 亚铁血红素 血红蛋白(四聚体) 珠蛋白 (月桂基
图片尺寸1080x810